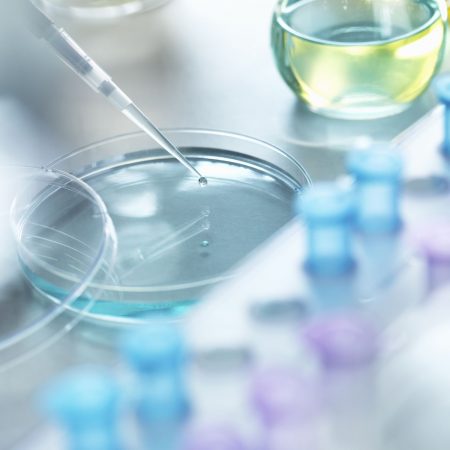
WWW

Delivered


on-market products

Laboratory Research &
Pharmaceutical company

and export opportunities for our portfolio

Laboratory Research &
Pharmaceutical company

Nature Together
Leading the Future of Health
Biotec Pharma aims to connect professionals with organizations in Pharmaceutical and Laboratory automation.
About us24/7 Customer Service
Top Management Team
About us
Dedication & Quality
We seek the new science
Biotec Pharma is a top Medical Laboratory Research, Pharmaceutical, medicine, and vaccine company with many years of experience focusing on value medicine and a vaccine to provide quality needs.
Our dedication to quality in everything we do is uncompromising, and covers every stage of the development, production and marketing of our medicines: from the supply of materials through manufacturing and approval by the strictest authorities in the world.
Our state-of-the-art manufacturing facilities feature the most advanced testing equipment to guarantee the quality of our products. Equipment is tested and certified, and every manufacturing process is validated. All supplier procedures are strictly supervised to ensure that only the highest grade materials are used in our product

Bringing Bio- pharmaceutical creativity to world market
Biotec Pharma specialize in the development, regulatory approval and commercialization of medicines that are currently unlicensed but have an existing patient need and prescriber demand. Biotec Pharma are dedicated to making medicines more manageable for patients and healthcare professionals.
We also offer a range of out-licensing and export opportunities for our portfolio. In addition to this, our business development team are continuously looking for complementary in-licensing options.
You will learn more from FAQ
YOUR GLOBAL PARTNER
In today’s challenging lab environments, the demand for higher productivity, streamlined workflows, superior quality and more reliable results is essential.
Biotec can help you meet that challenge. As the trusted global partner to leading clinical and diagnostic research labs around the world, we deliver advanced genetic testing solutions — all backed by our full commitment to innovative products, knowledgeable service and experienced customer support.

Some reviews from our clients

Sheila Coredero

Jewel D Smith